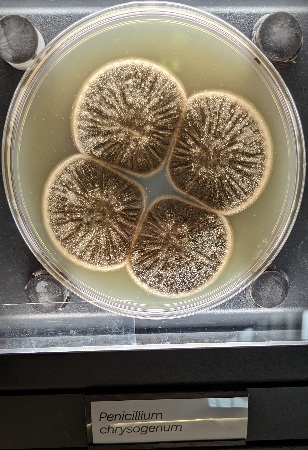

We took a tour on a canal boat of course.
This is what it looked like long, narrow and, low.

The Captain on this boat.

These houses have lifting beams (verhuishaak) used when raising goods or furniture to the upper stories.

A ship under sail that we saw beyond the city bridges.

The door to a lock that would be used to protect the city from flooding in the event of a major storm.

Mini Jeep? Nope it is a Micro Electric car called the "me" Available from Move Citycar.

There are seven bridges lined up over this canal.

Drawbridges

The Blauwbrug (blue bridge) built in 1883. At each end the lampposts are topped with the imperial crown.


Boats that have become homes. One with a tulip garden.


Buildings are constructed on wooden pilings sunk into the mud.
These are prone to settle unevenly resulting in some leaning at strange angles.

The Montelbaanstoren tower. Built in 1516 as part of the defense of the city.

We sailed past the NEMO Science Museum.

And as we were returning to where we started we passed the Sea Palace Restaurant.

We also visited Microbia a museum of microbes
There were a couple of Tardigrade models known colloquially as water bears or moss piglets.
They were 3000 to 4000 times their actual size


One wall was decorated with this piece of art.
It looks like a colony of microbes you might find on something that had been forgotten in the back of your refrigerator.

A model of a coronavirus and one of the suspected intermediate hosts, a pangolin, that led to COVID-19

And models of two other viruses.

You could check water quality from swimming areas.

A reproduction of a drawing by Anton van Leeuwenhoek (1632-1723) the: father of micromorphology and discoverer of spermatozoa.

There was a display of foods and drinks that depend on microbes to be made.

This and other sweet desert wines rely on a gray mold fungus that infects the skin of the grapes.
It makes them lose water resulting in a higher sugar content and produces a sweeter wine.
It is referred to as noble rot.

And this showed another of the products, pretzels, that depend on microbes.

Also on display were cheeses of all kinds, soy sauce, sunflower oil, and many more products.
There was a display of agar plates that had microbes growing on them.


There are more than 300 varieties of penicillium.
In many cases they can be distinguished by the patterns they make on agar plates.

The same variety of Penicillium grown on different media show different forms.


Here is a plate covered with Escherichia coli bacteria with 5 spots of a penicilium mold that have produced something that has killed the bacteria.
Dr. Alexander Fleming's investigation of this effect led to the development of the first antibiotic, penicillin.

Rhizobium leguminosarum is a bacterium which lives in a mutualistic symbiotic relationship with legumes, and has the ability to fix free nitrogen from the air.

The Zoo was right next to the museum so we took a brief walk through it as well.
The Scimitar oryx is extinct in the wild but zoos have a breeding program that maintains a small population.


Nearby there was a colony of meerkats.
This one looks annoyed, he was giving us the side eye.

There was lots more to see around town so we didn't spend much time at the zoo.
I did get a few pictures of flowers.
Poppies, Morning glories, and of course Tulips.





A few more sights around town.
The train station.

We were lost and wandering about and were startled when this carillon began to play.
There are casual restaurants all over the city.
The name of this one was Cafe Binnen Buiten, literally cafe inside outside.

Rijksmuseum Amsterdam, home of the Dutch masters

We drove through Amsterdam's red light district
You aren't supposed to take pictures of the ladies but since she was photographing us I thought it was only fair.
